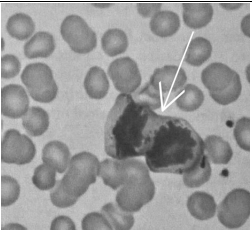
Enunciado 733030-1

Foram encontradas 120 questões.
Julgue o item, acerca da seguinte proposição:
P: “A nomeação do novo servidor público ocorre para reposição de vacância em área essencial, ou o candidato aprovado não será nomeado”.
A negação da proposição P está corretamente expressa por: “Ou a nomeação do novo servidor público ocorre para reposição de vacância em áreas não essenciais, ou o candidato aprovado será nomeado”.
Provas
Em um processo de coleta de fragmentos papilares para posterior identificação de criminosos, uma equipe de 15 papiloscopistas deverá se revezar nos horários de 8 h às 9 h e de 9 h às 10 h.
Com relação a essa situação hipotética, julgue o item a seguir.
Considere que uma dupla de papiloscopistas deve ser escolhida para atender no horário das 8 h. Nessa situação, a quantidade, distinta, de duplas que podem ser formadas para fazer esse atendimento é inferior a 110.
Provas
O resultado de uma pesquisa acerca da satisfação de 200 papiloscopistas, no que diz respeito às tarefas por eles executadas de identificação de vítimas e de descobertas de crimes de falsificação, foi o seguinte:
• 30 papiloscopistas sentem-se igualmente satisfeitos ao executar qualquer uma dessas tarefas;
• 180 papiloscopistas sentem-se satisfeitos ao executar pelo menos uma dessas tarefas.
Considerando que todos os 200 papiloscopistas responderam à pesquisa, julgue o item seguinte.
A quantidade de papiloscopistas que se sentem satisfeitos ao executar exatamente uma das referidas tarefas é superior a 100.
Provas
Julgue o item, acerca da seguinte proposição:
P: “A nomeação do novo servidor público ocorre para reposição de vacância em área essencial, ou o candidato aprovado não será nomeado”.
A proposição P é logicamente equivalente à proposição: “Não é verdade que o candidato aprovado será nomeado, a não ser que a nomeação do novo servidor público ocorra para reposição de vacância em área essencial”.
Provas
Provas
Provas
No item que se segue, é apresentada uma situação hipotética, seguida de uma assertiva a ser julgada com base em disposições das Leis n.os 8.069/1990, 12.037/2009 e 13.445/2017 e suas alterações.
Um indivíduo foi preso e a autoridade judiciária decidiu, de ofício, pela sua identificação criminal, por entender que tal medida seria essencial às investigações policiais. Nessa situação, a identificação criminal é legal e incluirá o processo datiloscópico e o fotográfico, podendo incluir também a coleta de material genético para a obtenção do perfil genético.
Provas
No item que se segue, é apresentada uma situação hipotética, seguida de uma assertiva a ser julgada com base em disposições das Leis n.os 8.069/1990, 12.037/2009 e 13.445/2017 e suas alterações.
Um estrangeiro reside no Brasil há quatro anos e não possui nenhuma condenação penal. Nessa situação, se esse estrangeiro tiver capacidade civil, segundo a lei brasileira, e comunicar-se em língua portuguesa, a ele poderá ser concedida a naturalização extraordinária.
Provas
Na tentativa de entrar em território brasileiro com drogas ilícitas a bordo de um veículo, um traficante disparou um tiro contra agente policial federal que estava em missão em unidade fronteiriça. Após troca de tiros, outros agentes prenderam o traficante em flagrante, conduziram-no à autoridade policial local e levaram o colega ferido ao hospital da região.
Nessa situação hipotética,
caso o traficante tenha se identificado com carteira nacional de habilitação rasurada, sua identificação criminal deverá ser feita pelo processo datiloscópico.
Provas
O resultado de uma pesquisa acerca da satisfação de 200 papiloscopistas, no que diz respeito às tarefas por eles executadas de identificação de vítimas e de descobertas de crimes de falsificação, foi o seguinte:
• 30 papiloscopistas sentem-se igualmente satisfeitos ao executar qualquer uma dessas tarefas;
• 180 papiloscopistas sentem-se satisfeitos ao executar pelo menos uma dessas tarefas.
Considerando que todos os 200 papiloscopistas responderam à pesquisa, julgue o item seguinte.
A probabilidade de que um papiloscopista, escolhido ao acaso, tenha se dito igualmente satisfeito ao executar qualquer uma entre as duas tarefas mencionadas, dado que se sente satisfeito ao executar pelo menos uma das duas tarefas, é inferior a 0,15.
Provas
Caderno Container